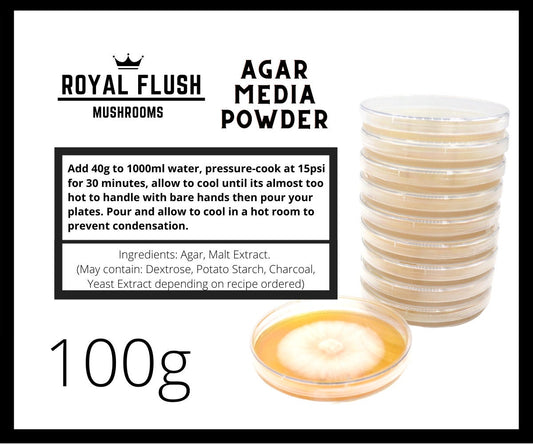
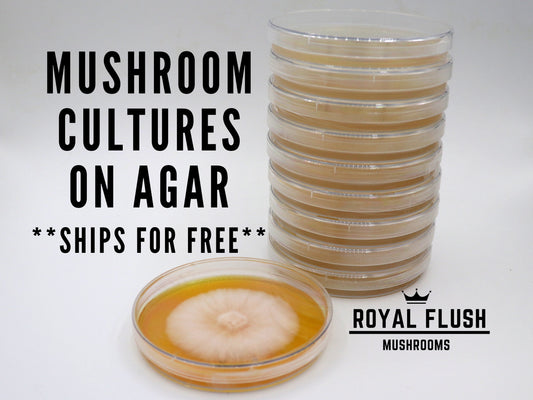

Products
Clean, high-quality commercial production strains selected for high-yield, growth parameters and shelf life of the final product.
-
Complete Fruiting Chamber with 6 PF TEK Jars, Sprayer and Vermiculite
Regular price $99.99Regular price -
Custom order for Kay
Regular price $320.00Regular price -
Filter Stickers For Spawn Lids - Free Shipping - Keeps Your Spawn Clean!
Regular price $14.99Regular price -
Grain Spawn Jar- With Injection Port
Regular price $14.99Regular price -
Gypsum for Mushroom Growing - Organic - 1lb
Regular price $9.99Regular price -
Hardwood Pellets
Regular price $19.99Regular price -
Jar of Sterilized Liquid Culture Base
Regular price $19.99Regular price -
Lion's Mane Mushroom Grow Kit
Regular price $27.99Regular price -
Liquid Culture 10 Pack - Choose from 22 Kinds
Regular price $89.99Regular price -
Liquid Culture Jar Lid - Autoclavable PP5
Regular price $9.99Regular price -
Liquid Culture Kit - Stir Plate&Bar, Quart Jar, LC Lid, and LC PreMix
Regular price $79.99Regular price -
Malt Extract Agar Powder Mix - Any Recipe Your Choice
Regular price $9.99Regular price -
Master's Mix Substrate -Sterile, Hydrated, Ready-to-use (In 14A Mushroom Grow Bag)
Regular price $24.99Regular price -
Monotub Kit - Sterile Spawn and Substrate Kit - Just Add Spores
Regular price From $39.99Regular price -
Mushroom Culture on Agar - Commercial Production Strains
Regular price $17.99Regular price -
Mushroom Grow Bags - Royal Flush Brand (100pcs.) (4 sizes)
Regular price $99.99Regular price -
Mushroom Grow Bags - Royal Flush Brand (10pcs.) (4 sizes)
Regular price $13.99Regular price -
Mushroom Grow Kit - Enoki
Regular price $24.99Regular price -
Mushroom Grow Kit - Free Shipping
Regular price $40.00Regular price -
Mushroom Grow Kit - Lion's Mane
Regular price From $24.99Regular price -
Mushroom Grow Kit -Lion's Mane- Ships Free
Regular price $39.99Regular price -
Mushroom Grow Kit -Oyster- Ships Free
Regular price $39.99Regular price -
Mushroom Grow Kit -Turkey Tail - Ships Free to USA and Canada!
Regular price $39.99Regular price -
Mushroom Grow Kit Mixed Bundle - 4 Pack
Regular price $79.99Regular price


Check back soon for tutorials!
We will be adding tutorials showing you how to do everything from making your own grain spawn, liquid cultures, substrates and more.
Subscribe to our emails
Be the first to know about new collections and exclusive offers.